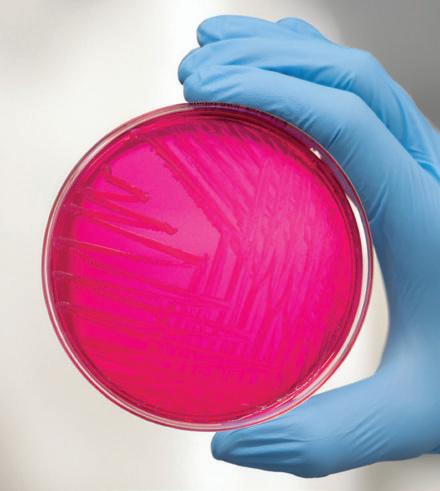

![]()



Fiona
Schoemaker-van Kaam1, Annet Heuvelink1, Remco Dijkman1, Christiaan ter Veen1, Sible Westendorp2 & Anneke Feberwee1 1Royal GD, Deventer, the Netherlands, 2DAP Kippendokter, Hoeven, the Netherlands
Background
• Salmonella enterica subspecies enterica serovar Gallinarum biovar Pullorum (SP) is a non-motile, host specific pathogen for poultry
• The Animal Health Regulation (AHR) EU2019/2035 prescribes the control of SP in commercial poultry (1)
• SP in commercial poultry industry is minimized due to organized control programs, however, SP outbreaks still occur in non-commercial poultry (2)
• In this study, an SP outbreak investigation was performed using different diagnostic matrices, including those described in the AHR (1)
• Whole Genome Sequencing (WGS) was performed to examine the relatedness of the isolates
Methods
• SP was isolated from different tissue samples in two submissions of young chickens from a non-commercial poultry trade location
• Both submissions were related to source A and B
• For outbreak investigation, source A and B were visited and different samples were collected, including matrices described in the AHR
• Diagnostic matrices, processing and identification of Salmonella isolates are presented in figure 1
• WGS data of the SP isolates from the two initial submissions and source A and B were both mutually compared and with data of Dutch historical and publicly available foreign SP isolates
Results
• In total, five SP isolates were obtained from both submissions from the trade location
• For source A, SP was isolated from a down/meconium sample, gut content of embryos in unpipped eggs and from 13-days-incubated fertile eggs. Multiple serum samples from a parent flock of one breed tested positive (table 1)
• For source B, no SP was isolated from the matrices tested (table 1)
• WGS revealed three genetically different genotypes as presented in figure 2
• One genotype was related to source A, a second one to a historical SP genotype from 2023 related to source B and a third one to historical Dutch SP isolates from earlier years from non-commercial poultry
Conclusion
The results of this outbreak investigation prove that SP can be isolated from different matrices, those prescribed by the AHR and non-AHR matrices. WGS supported the link with source A and other isolates clustered with historical Dutch isolates both from source B and other isolates from non-commercial poultry.
Table 1. Diagnostic matrices, number of samples and SP positives source A and B Diagnostic matrix
or second grade chicks


Non-AHR
Fresh hatching eggs











Non-AHR
13-daysincubated eggs AHR
Unpipped eggs/deadin-shell embryos

Downmeconium from hatcher






*Positive samples originated from the same breed. **Mixed samples from different breeds.
Molenaar R.J. et al., Avian Pathology, 53:44-55, 2024 3. Xiong D. et al., Frontiers in Microbiology, 9:1718, 2018



f.schoemaker@gddiergezondheid.nl
node (Cluster 1), dark blue node (Cluster 2) or yellow node (Cluster 3). References 1. Animal Health Law (AHL) (2016), Regulation (EU) 2016/429
2. Phylogenetic SNP tree based on 4372 informative SNPs from 36 Salmonella Pullorum isolates and using Salmonella Pullorum strain ATCC 9210 as reference (CP012347). Data were clustered using the neighbour joining method and the Jukes Cantor nucleotide substitution model. Country of origin and year of isolation, as well as genotypes found in submission 1 and 2 of the trade location (TL1 & TL2), Source A and historical isolates from Source B are indicated. Isolates belonging to distinct clusters are indicated with a